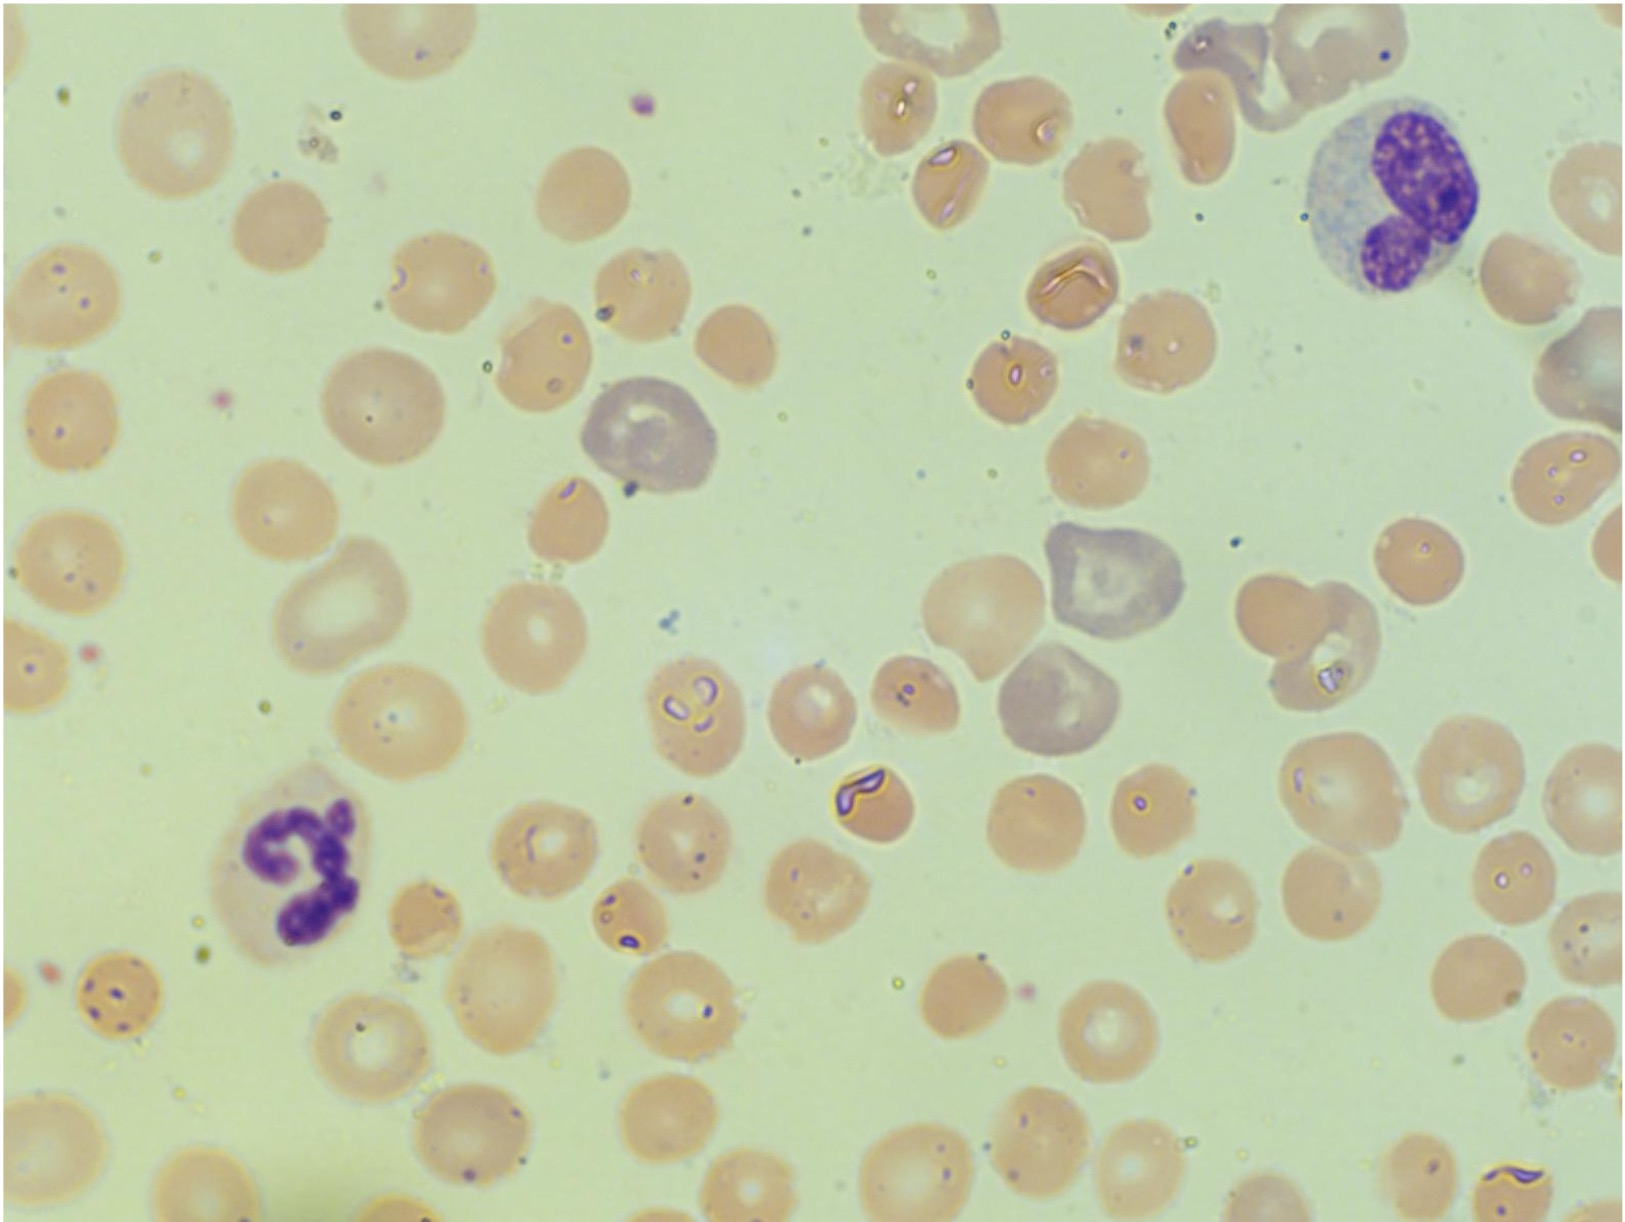
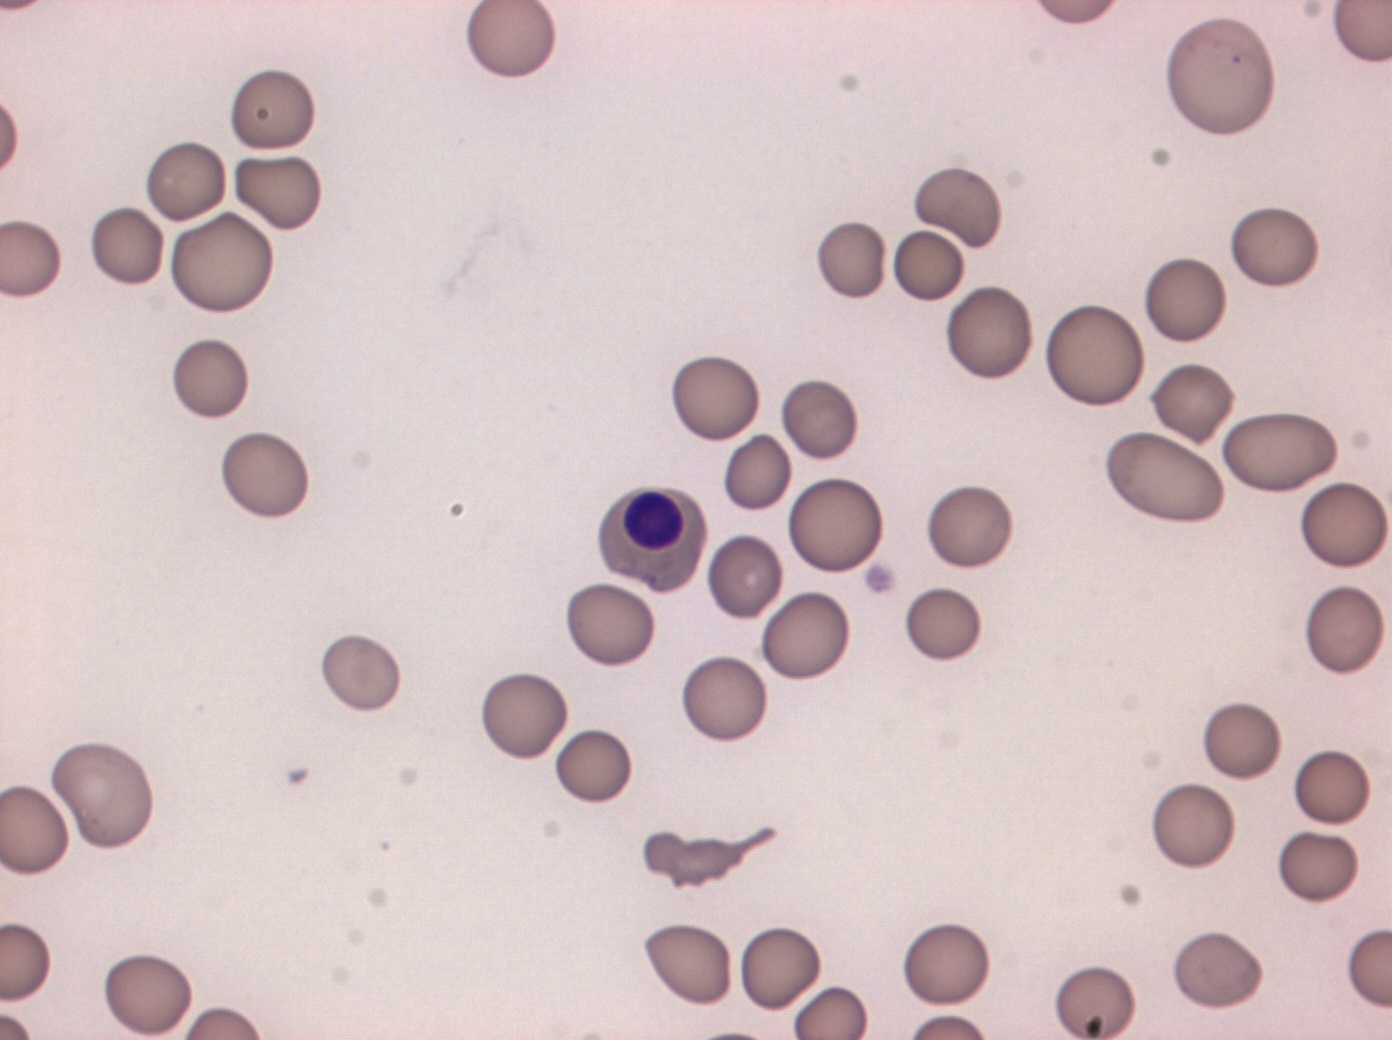

Ретикулоциты 0 1
Ретикулоциты 0 1 113 фотографий
Фамилия полищук склоняется
Гипофиз что это такое лечение
Амурский б хабаровск
Фукорцин слизистая рта
5 глаголов с не раздельно
Ремонт генераторов в зеленограде
San andreas код на летающую машину
Smooth tight
Шевченко 85 1
Алеан ривьера фото